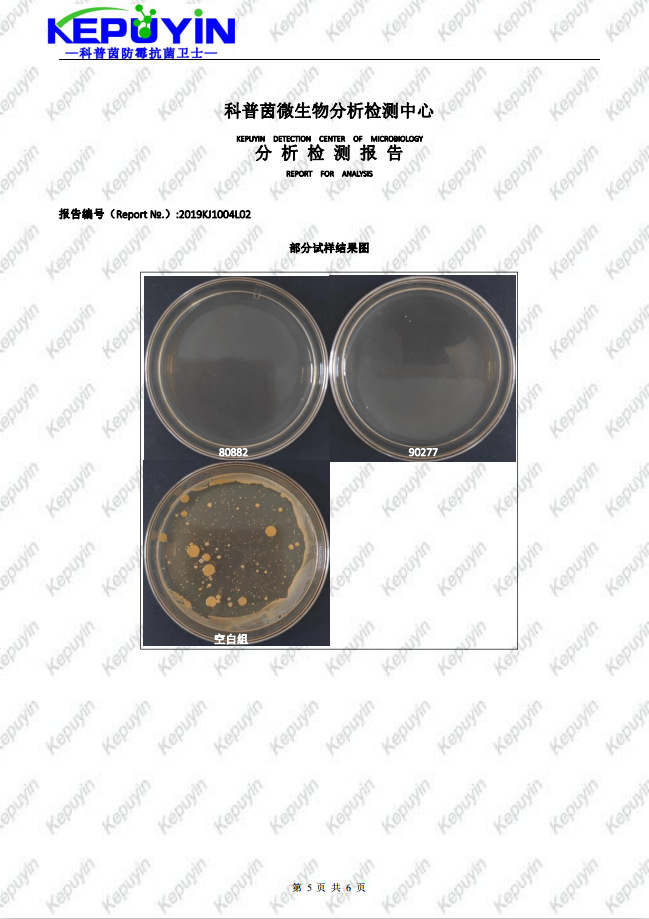
undefined

塑料抗菌剂 耐高温透明ABS抗菌剂应用
- 供应商
- 佛山科普茵生物科技有限公司
- 认证
- 品牌
- KEPUYIN
- 型号
- KEPUYIN-J151
- 产地
- 广东
- 联系电话
- 0757-88788686
- 手机号
- 18620907734
- 经理
- 陈师
- 所在地
- 佛山市南海区大沥镇盐步横江横沙路88号厂房的2楼(住所申报)
- 更新时间
- 2021-10-22 10:54



塑胶抗菌剂KEPUYIN-J151,是应用先进安全环保无机抗菌剂复配而成。该抗菌剂由超细片层型磷酸锆载体上进行银锌插层反应而成,粒径达到微米级;具有极高的安全性,无毒、无刺激、不燃、无色无味,效能持久耐水洗。目前已广泛应用各种家电、卫浴、日用品、纺织品、水管、包装材料上。


*抗菌性能优异、杀菌广谱;
*理化性质稳定,耐高温,耐酸碱,耐紫外线,效果持久;
*属于非溶出型抗菌添加剂,洗涤50次后抗菌率大于99%;
*安全无毒,无刺激性,无致敏性,不造成污染,环保,符合欧盟RoSH标准要求;
*粒径小,比面积高,作用高效,可用于薄膜、纤维等特殊场合。


家电、卫浴、日用品、纺织品、水管、包装等抗菌要求。尤其适用于以PP/PE/ABS/HIPS/PVC/PBT等为基料的注塑和挤出制品,如可以制成抗菌冰箱、抗菌洗衣机、抗菌电话、抗菌菜板、抗菌玩具、抗菌键盘、抗菌门把手、抗菌方向盘、抗菌牙刷、抗菌马桶盖板、抗菌医疗器械等等。

※建议添加量为0.6~1%,直接和分散剂或者色粉搅拌均匀,通过注塑,吹塑等工艺制作成成品即可。
※建议先造粒,做成10~20%的抗菌母粒,Zui终的添加量为0.6~1%,再次和母粒混合搅拌均匀后,进行注塑,吹塑等工艺。

塑胶抗菌剂KEPUYIN-J151主要成分作用机制是当微量的Ag+Zn2+到达微生物细胞膜时,因后者带负电荷,依靠库仑引力,使两者进行吸附,Ag+Zn2+穿透细胞壁进入细胞内,并与巯基(-SH)反应,使蛋白质凝固,破坏细胞合成酶的活性,细胞丧失分裂繁殖能力而死亡。
测试标准
*QB/T2591-2003 抗菌塑料-抗菌性能试验方法和抗菌效果,附录A:抗菌塑料-抗细菌性能试验方法
* JISZ2801-2000 抗菌产品抗菌活性和效果的试验
* AATCC100-2004 纺织材料抗菌整理剂的评定
* GB/T 20944纺织品 抗菌性能评价
* JIS L1902-2008 纺织品抗菌性能的检测与评价

注意事项
使用操作时必须戴手套、防护口罩和护目镜,避免接触皮肤。一旦大量吸入和眼睛接触立即用大量清水及肥皂清洗并及时就医。
包装储存
包装及规格:化工纸装,25kg/桶。密封储存,避免吸潮后不易分散。





